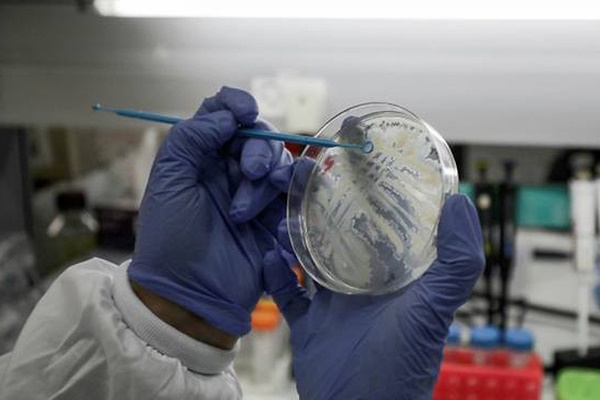
Điều gì xảy ra nếu thế giới vẫn chưa tìm ra vaccine ngừa Covid-19?-1

Các nhà khoa học trên thế giới đang chạy đua trong việc phát triển vaccine chống Covid-19. Ảnh: AFP
Không có gì đảm bảo chúng ta chắc chắn sẽ sớm có vaccine phòng ngừa Covid-19. Do đó, chúng ta cần nghiên cứu nhằm hiểu được những cách tốt nhất để đeo khẩu trang, rửa tay cũng như các biện pháp can thiệp khác nhằm kiểm soát sự lây lan của dịch bệnh.
Đường cong dịch Covid-19 đã được "làm phẳng" ở nhiều quốc gia trên thế giới nhưng vẫn chưa có bất kỳ loại thuốc chống virus hay loại vaccine mới nào được hoàn thành.
Chúng ta cho đến nay chủ yếu vượt qua dịch bệnh chủ yếu nhờ các biện pháp can thiệp không sử dụng thuốc như cách ly, giãn cách xã hội, rửa tay, và với các nhân viên y tế thì là dùng khẩu trang và các thiết bị bảo hộ khác.
Tất cả chúng ta đều hy vọng sẽ có một loại vaccine vào năm 2021. Nhưng trong thời gian chờ đợi đó, chúng ta nên làm gì? Và quan trọng hơn, điều gì xảy ra nếu vaccine không xuất hiện trong tương lai gần?
Thế giới đã đánh cược hầu hết các nguồn quỹ nghiên cứu vào việc tìm kiếm vaccine và các loại thuốc hiệu quả chống Covid-19. Không thể phủ nhận nỗ lực này là cần thiết, song nỗ lực này cần phải đi cùng với những nghiên cứu về việc làm thế nào để hướng tới cũng như cải thiện các biện pháp can thiệp không dùng thuốc, vốn là những cách hiệu quả duy nhất để đối phó với dịch bệnh hiện nay.
Đã có nhiều cuộc tranh luận nổ ra về những câu hỏi cơ bản như liệu công chúng có nên sử dụng khẩu trang hay không, liệu chúng ta nên đứng cách nhau 1, 2 hay 4 mét và liệu chúng ta có nên rửa tay bằng xà phòng hoặc nước sát khuẩn hay không? Đó là những câu hỏi mà chúng ta cần trả lời ngay lập tức.
Những biện pháp can thiệp không dùng thuốc là gì?
Theo giới nghiên cứu y tế, các biện pháp không dùng thuốc là đối tượng của khoảng 40% các cuộc thử nghiệm lâm sàng. Tuy nhiên, các biện pháp này ít nhận được sự chú ý hơn nhiều so với việc phát triển thuốc và các loại xét nghiệm.
Trong đại dịch Covid-19, rất nhiều tiền đã được dành ra cho các nhóm nghiên cứu trên khắp thế giới nhằm phát triển vaccine và các đợt thử nghiệm thuốc có tiềm năng chống lại virus.
Hàng trăm cuộc thử nghiệm lâm sàng đối với thuốc và vaccine đang diễn ra nhưng chúng ta chỉ có thể tìm thấy một vài cuộc thử nghiệm đối với các biện pháp can thiệp không dùng thuốc và đặc biệt, không có cuộc thử nghiệm nào về việc làm sao để cải thiện các biện pháp này.
Cả thế giới dồn nỗ lực và hy vọng vào việc phát triển thành công một loại thuốc hoặc một loại vaccine điều trị Covid-19 . Tuy nhiên, nhiều chuyên gia, trong đó có Ian Frazer - người phát triển vaccine HPV của Australia nhận định việc này sẽ không dễ dàng và cũng không nhanh chóng.
Nếu một vaccine hoặc một loại thuốc chống virus hiệu quả vẫn chưa xuất hiện, chúng ta cần một Kế hoạch B sử dụng các biện pháp can thiệp không dùng thuốc. Đó là lý do tại sao chúng ta cần các nghiên cứu chất lượng cao nhằm xác định những biện pháp nào hiệu quả và làm sao để chúng phát huy hiệu quả tốt nhất có thể.
Tầm quan trọng của việc nghiên cứu các biện pháp không dùng thuốc
Chúng ta thường nghĩ rửa tay, đeo khẩu trang, giãn cách xã hội là những biện pháp đơn giản và không cần phải nghiên cứu. Trên thực tế, các biện pháp can thiệp không dùng thuốc thường phức tạp hơn nhiều.
Phát triển và thực hiện một biện pháp can thiệp không dùng thuốc rất khác với việc phát triển một loại vaccine hay một loại thuốc.
Lấy ví dụ, chúng ta có một chiến lược "khẩu trang cho mọi người" (#Masks4All) để khuyến khích mọi người đeo khẩu trang. Nhưng các câu hỏi đặt ra là chúng ta cần đeo loại khẩu trang nào, và chất liệu của khẩu trang nên là gì? Đeo khi nào và đeo ở đâu? Hầu như có rất ít cuộc thảo luận về những câu hỏi cụ thể trên.
Hay rửa tay nghe có vẻ là một biện pháp đơn giản nhưng chúng ta nên rửa tay bao nhiêu lần? 2 lần/ngày, 10 lần/ngày hay một con số cụ thể nào khác? Cách tốt nhất để dạy mọi người rửa tay đúng cách là gì?
Bên cạnh đó, liệu rửa tay bằng nước rửa tay khô có tốt hơn rửa với xà phòng và nước hay không? Đeo khẩu trang và rửa tay cái nào hiệu quả hơn hay là cả 2 biện pháp này?
Đó chỉ là một vài trong số rất nhiều điều khác chúng ta không biết về các biện pháp can thiệp không dùng thuốc.
Các lựa chọn không dùng thuốc khác cũng rất rộng, trong đó bao gồm việc nghiên cứu về môi trường, chẳng hạn như nhiệt độ, điều kiện không khí, các bề mặt (chẳng hạn như SARS-CoV-2 "chết" nhanh hơn trên bề mặt đồng so với các bề mặt cứng khác).
Ngoài ra, liệu có một biện pháp phòng chống dịch nào đó hiện nay chúng ta đang thực hiện mà không có hiệu quả hay không? Có lẽ có. Nhưng vấn đề là chúng ta không biết đó là cái nào. Chúng ta cần biết điều này càng sớm càng tốt bởi chúng ta không nên lãng phí thời gian, công sức và nguồn lực vào những biện pháp không hiệu quả.
Đại dịch tiếp theo
Nếu thành công trong việc phát triển vaccine chống Covid-19, chúng ta coi như "thoát nạn" trong đại dịch hiện nay. Nhưng điều gì xảy ra nếu đại dịch tiếp theo hoặc các đợt bùng phát dịch bệnh khác xuất hiện.
Vaccine chỉ có thể chống lại loại virus nhất định, vì thế nếu có một loại virus mới đe dọa chúng ta vào lần sau, chúng ta sẽ lại rơi vào tình cảnh tương tự như trong đại dịch Covid-19 hoặc thậm chí tồi tệ hơn.
Tuy nhiên, những điều chúng ta rút kinh nghiệm hiện nay từ những biện pháp can thiệp không dùng thuốc có thể sẽ hữu ích để bảo vệ chúng ta trước các loại virus khác, trong khi chờ đợi thuốc hoặc vaccine mới ra đời.
Chúng ta đã có cơ hội để nghiên cứu về các biện pháp can thiệp không dùng thuốc đối với những loại virus về hô hấp trước đây, đặc biệt là trong dịch SARS năm 2003 và dịch cúm H1N1 năm 2009.
Tuy nhiên, nhiều cơ hội để phân tích sâu hơn đã bị lãng phí và chúng ta hiện đang phải tự tìm kiếm trong tuyệt vọng câu trả lời cho những câu hỏi từng được đặt ra.
Nghiên cứu Kế hoạch B
Để chuẩn bị cho tương lai và Kế hoạch B, trong trường hợp mà vaccine không xuất hiện, chúng ta cần tiến hành các cuộc thử nghiệm lâm sàng ngẫu nhiên với các biện pháp không dùng thuốc để ngăn chặn sự lây lan của các virus về hô hấp.
Đại dịch hiện nay đang cho chúng ta một cơ hội hiếm có để nhanh chóng tiến hành các cuộc thử nghiệm, trả lời cho nhiều câu hỏi chúng ta không biết về một loạt các biện pháp can thiệp không dùng thuốc.
Nghiên cứu vaccine và thuốc chống lại virus là con đường tối ưu nhất để vượt qua đại dịch Covid-19, nhưng việc tập trung tất cả tài chính, nỗ lực và nguồn lực vào các nghiên cứu này có thể biến thành một sai lầm đắt giá, đồng thời gây ra tổn hại cả về y tế và kinh tế giống như canh bạc “được ăn cả, ngã về không”. Do đó, chúng ta luôn cần một Kế hoạch B để đối phó với dịch bệnh, không chỉ riêng với dịch Covid-19 mà còn cả những đại dịch trong tương lai./.
Theo VOV
